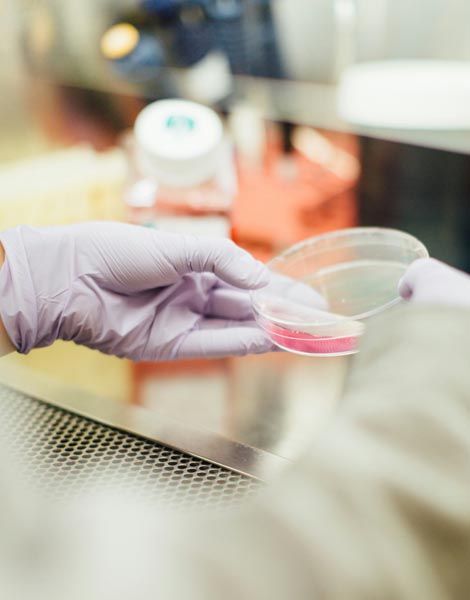

학부소개
융합적 사고와 역량을 갖춘
창의적이고 혁신적인 인재양성
안녕하세요, 한양대학교 ERICA캠퍼스 첨단융합대학 바이오신약융합학부 학부장 황승용입니다.
우리 학부는 바이오신약 분야의 혁신과 발전을 선도하는 인재를 양성하기 위해 최선을 다하고 있습니다. 첨단 바이오 신약 기술과 바이오 나노 공학기술의 융합을 통해, 우리는 미래의 건강과 복지를 책임질 수 있는 전문가를 배출하고자 합니다.
우리 학부의 교육 프로그램은 이론과 실습을 균형 있게 배합하여 학생들이 실제 현장에서 필요한 지식과 기술을 습득할 수 있도록 설계되었습니다. 또한, 국내외 유수의 연구기관 및 산업체와의 협력을 통해 학생들이 다양한 경험을 쌓고, 글로벌 경쟁력을 갖출 수 있도록 지원하고 있습니다.
바이오신약융합학부는 학생들의 창의성과 도전 정신을 존중하며, 각자의 꿈을 실현할 수 있는 환경을 제공하고자 합니다. 여러분의 열정과 노력이 더해져, 우리 학부는 더욱 빛나는 미래를 향해 나아갈 것입니다.
감사합니다.
황승용
한양대학교 ERICA캠퍼스 첨단융합대학 바이오신약융합학부 학부장